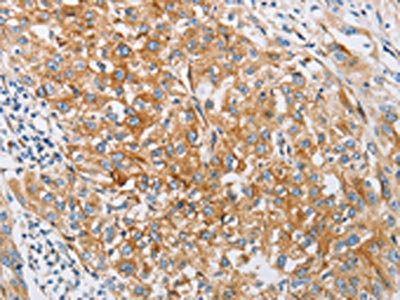

IFITM3 Antibody
-
中文名稱:IFITM3兔多克隆抗體
-
貨號:CSB-PA200236
-
規格:¥1100
-
圖片:
-
The image on the left is immunohistochemistry of paraffin-embedded Human breast cancer tissue using CSB-PA200236(IFITM3 Antibody) at dilution 1/25, on the right is treated with fusion protein. (Original magnification: ×200)
-
The image on the left is immunohistochemistry of paraffin-embedded Human esophagus cancer tissue using CSB-PA200236(IFITM3 Antibody) at dilution 1/25, on the right is treated with fusion protein. (Original magnification: ×200)
-
Gel: 12%SDS-PAGE, Lysate: 40 μg, Lane 1-3: Hela cells, hepg2 cells, A375 cells, Primary antibody: CSB-PA200236(IFITM3 Antibody) at dilution 1/500, Secondary antibody: Goat anti rabbit IgG at 1/8000 dilution, Exposure time: 10 seconds
-
-
其他:
產品詳情
-
Uniprot No.:
-
基因名:IFITM3
-
別名:1 8U antibody; Fragilis antibody; IFITM3 antibody; IFM3_HUMAN antibody; Interferon induced transmembrane protein 3 (1 8U) antibody; Interferon Induced Transmembrane Protein 3 antibody; Interferon inducible antibody; Interferon inducible protein 1 8U antibody; Interferon Inducible Protein 15 antibody; Interferon Inducible Protein Homolog antibody; Interferon-induced transmembrane protein 3 antibody; Interferon-inducible protein 1-8U antibody; IP15 antibody
-
宿主:Rabbit
-
反應種屬:Human
-
免疫原:Fusion protein of Human IFITM3
-
免疫原種屬:Homo sapiens (Human)
-
標記方式:Non-conjugated
-
抗體亞型:IgG
-
純化方式:Antigen affinity purification
-
濃度:It differs from different batches. Please contact us to confirm it.
-
保存緩沖液:-20°C, pH7.4 PBS, 0.05% NaN3, 40% Glycerol
-
產品提供形式:Liquid
-
應用范圍:ELISA,WB,IHC
-
推薦稀釋比:
Application Recommended Dilution ELISA 1:2000-1:10000 WB 1:1000-1:5000 IHC 1:25-1:100 -
Protocols:
-
儲存條件:Upon receipt, store at -20°C or -80°C. Avoid repeated freeze.
-
貨期:Basically, we can dispatch the products out in 1-3 working days after receiving your orders. Delivery time maybe differs from different purchasing way or location, please kindly consult your local distributors for specific delivery time.
-
用途:For Research Use Only. Not for use in diagnostic or therapeutic procedures.
相關產品
靶點詳情
-
功能:IFN-induced antiviral protein which disrupts intracellular cholesterol homeostasis. Inhibits the entry of viruses to the host cell cytoplasm by preventing viral fusion with cholesterol depleted endosomes. May inactivate new enveloped viruses which buds out of the infected cell, by letting them go out with a cholesterol depleted membrane. Active against multiple viruses, including influenza A virus, SARS coronaviruses (SARS-CoV and SARS-CoV-2), Marburg virus (MARV), Ebola virus (EBOV), Dengue virus (DNV), West Nile virus (WNV), human immunodeficiency virus type 1 (HIV-1), hepatitis C virus (HCV) and vesicular stomatitis virus (VSV). Can inhibit: influenza virus hemagglutinin protein-mediated viral entry, MARV and EBOV GP1,2-mediated viral entry, SARS-CoV and SARS-CoV-2 S protein-mediated viral entry and VSV G protein-mediated viral entry. Plays a critical role in the structural stability and function of vacuolar ATPase (v-ATPase). Establishes physical contact with the v-ATPase of endosomes which is critical for proper clathrin localization and is also required for the function of the v-ATPase to lower the pH in phagocytic endosomes thus establishing an antiviral state. In hepatocytes, IFITM proteins act in a coordinated manner to restrict HCV infection by targeting the endocytosed HCV virion for lysosomal degradation. IFITM2 and IFITM3 display anti-HCV activity that may complement the anti-HCV activity of IFITM1 by inhibiting the late stages of HCV entry, possibly in a coordinated manner by trapping the virion in the endosomal pathway and targeting it for degradation at the lysosome. Exerts opposing activities on SARS-CoV-2, including amphipathicity-dependent restriction of virus at endosomes and amphipathicity-independent enhancement of infection at the plasma membrane.
-
基因功能參考文獻:
- Study showed that IFITM3 was upregulated in hepatocellular carcinoma (HCC) tissues and associated with HCC tumor size, tumor multifocal, and venous invasion. Furthermore, IFITM3 was identified as a new functional target gene of miR29a which expression was negatively correlated with that of IFITM3 in HCC tissues. These results indicated that IFITM3 play a critical role in the development and progression of HCC. PMID: 30272306
- a functional convergence between the mTOR pathway and IFITM3 proteins at endolysosomal membranes. PMID: 30301809
- We analyzed the population genetics of IFITM3 variants in the Portuguese general population (n = 200) and Central Africans (largely Angolan) (n = 148) as well as its association to influenza severity in Portuguese patients PMID: 28842783
- rs12252 C polymorphism of interferon-induced transmembrane protein 3 (IFITM3) is associated mild flu in Iranian population. Carriers of the rs12252 C allele (CT + CC genotypes) showed 5.92 folds increase in the risk of mild flu comparing to the T allele homozygotes. There is a significant positive association between rs12252 C allele heterozygote and mild flu but not in C allele homozygote group. PMID: 29121968
- A significant association between the IFITM3 rs12252 polymorphism and the risk of influenza in both the White and East Asian populations (meta-analysis). PMID: 29940276
- contrary to its role in enhancing DNA virus replication, LSD1 limits RNA virus replication by demethylating and activating IFITM3 which is a host restriction factor for many RNA viruses PMID: 29281729
- study predicts IFITM3 secondary structures and identifes a highly conserved, short amphipathic helix within a hydrophobic region of IFITM3 previously thought to be a transmembrane domain; show this helix and its amphipathicity are required for IFITM3-dependent inhibition of influenza virus, Zika virus vesicular stomatitis virus, Ebola virus and HIV infections PMID: 28835547
- frequencies of the CC genotype and the C allele in the IFITM3 polymorphism were higher in the Korean population than in the European populations but not in Chinese and Japanese populations; the rs12252 polymorphism of the IFITM3 gene did not significantly correlate with the disease severity of influenza A virus infection PMID: 28813716
- IFITM3 rs12252 CC genotype was associated with severity rather than susceptibility of IVI in Chinese population, and this strong effect was observed in all subtypes of seasonal influenza infection PMID: 28713779
- Identification of three distinct mutations that converted IFITM1 or IFITM3 from inhibitors to enhancers of MERS-CoV or SARS-CoV spike protein-mediated entry revealed key structural motifs or residues determining the biological activities of IFITM proteins. PMID: 29263263
- Results demonstrate that IFITM3 expression has a close relationship with prognosis in esophageal squamous cell carcinoma (ESCC) patients. Its overexpression may predict poor prognosis in stage IIA ESCC patients after Ivor Lewis esophagectomy. PMID: 28857475
- Study demonstrated, for the first time, that IFITM3 is expressed at a much higher level in lung cancer than in control tissues. Its knockdown could suppress lung cancer cell proliferation, invasion, and migration while inducing lung cancer cell cycle arrest and apoptosis. PMID: 28544512
- IFITM3 is upregulated in patient-derivedbrain tumor-propagating cells (BTPCs) upon irradiation but does not affect brain tumor formation or progression in vivo. PMID: 27835870
- These results indicate that IFITM3 protein can restrict alphavirus infection by inhibiting viral fusion with cellular membranes. PMID: 27219333
- The transcriptional regulation of IFITM1, 2 and 3 expression. PMID: 28511927
- IFITM1 and IFITM3 inhibit Zika virus infection early in the viral life cycle. PMID: 27268505
- We failed to confirm an association between the rs12252_C allele of IFITM3 and influenza susceptibility in 2 cohorts of children. PMID: 28531322
- homozygous IFITM3 CC and TLR3 CC genotypes showed significant independent associations with higher death risks in H7N9/H1N1pdm09 influenza in a large Chinese cohort PMID: 28510725
- We found evidence of a new association of rs34481144 with severe influenza in three cohorts characterized by different levels of influenza illness severity. rs34481144 is an expression quantitative trait locus (eQTL) for IFITM3, with the risk allele associated with lower mRNA expression. The risk allele was found to have decreased IRF3 binding and increased CTCF binding in promoter-binding assays. PMID: 28714988
- IFITM3 rs12252 variant was associated with respiratory infection hospitalization but not specifically in patients infected with Influenza A(H1N1)pdm09. PMID: 27351739
- findings show that the sensitivity of influenza A viruses to the IFN-induced antiviral state and IFITM2 and IFITM3 proteins depends on the pH value at which the viral HA undergoes a conformational transition and mediates membrane fusion PMID: 28356532
- cell-extrinsic and cell-intrinsic factors including IFITM3 have roles in regulating the efficiency and kinetics of virus entry and fusion with target cells PMID: 28341742
- Key features of the HIV-1 envelope protein that are associated with viral resistance to the IFITM3 protein. PMID: 28100616
- The study demonstrates that the human pulmonary endothelium possesses intrinsic immunity to human influenza viruses, in part due to the constitutive expression of IFITM3 proteins. PMID: 27707929
- The present study identified the transcripts, which were affected by the downregulation of endogenous IFITM3 and the pathways they were involved in. These findings may lead to an improved understanding of the biological functions of IFITM3. PMID: 27667301
- there is one transmembrane helix in the human IFITM3 with a possible role in virus entry PMID: 27046158
- These data do not suggest a role of rs12252-C in the development of severe influenza virus infection in the population. PMID: 27492307
- IFITM2 and IFITM3 specifically antagonize the HIV-1 envelope glycoprotein (Env), thereby inhibiting viral infection. PMID: 26387945
- we demonstrate that the E3 ubiquitin ligase NEDD4 ubiquitinates IFITM3 in cells and in vitro. PMID: 26263374
- propose that the IFITM proteins act in a coordinated manner to restrict HCV infection by targeting the endocytosed HCV virion for lysosomal degradation and demonstrate that the actions of the IFITM proteins are indeed virus and cell-type specific PMID: 26354436
- Our meta-analysis suggests a significant association between a minor IFITM3 allele (SNP rs12252-C) with severe influenza susceptibility, but not in mild influenza subjects PMID: 25942469
- A novel association between IFITM3 gene polymorphism and rapid disease progression is reported in an acute HIV-1-infected MSM cohort in China. PMID: 25784441
- This meta-analysis suggests that IFITM3 rs12252 T>C polymorphism is significantly associated with increased risk of severe influenza but not with the chance of initial virus infection. PMID: 25778715
- In virus-producing cells, IFITMs coalesce with forming virions and are incorporated into HIV-1 viral particles. PMID: 25422070
- Incorporation of IFITM1, IFITM2 and IFITM3 into HIV-1 virions impair viral fusion and spread. PMID: 25464829
- Authors suggest that IFITM3 adopts multiple membrane topologies involving at least one intramembrane domain in its antivirally active conformation. PMID: 25405885
- Taken together, these data suggested that IFITM3 is a potential therapeutic target for GC. PMID: 25270246
- Tyrosine 20 partially regulates the subcellular localization of IFITM3 but is not functionally essential for IFITM3-mediated H1N1 restriction. PMID: 25314048
- Host IFITM3,IFITM2 and IFITM1 facilitate morphogenesis of the human cytomegalovirus assembly. PMID: 25552713
- Exposure of A(H1N1)pdm09-infected epithelial cells to HIV-1 viral particles or its gp120 enhanced by 25% the IFITM3 content. resulting in a decrease in influenza replication. PMID: 24978204
- As an endocytic protein, IFITM3 first arrives at the plasma membrane before it is endocytosed and further traffics to the late endosomes where it acts to impede virus entry. PMID: 24521078
- IFITM3 may redirect IAV fusion to a non-productive pathway, perhaps by promoting fusion with intralumenal vesicles within multivesicular bodies/late endosomes. PMID: 24699674
- Authors found evidence of an association between rs12252 rare allele homozygotes and susceptibility to mild influenza (in patients attending primary care). PMID: 23997235
- The findings of this study provided new evidence that IFITM3 plays an important role in glioma cell growth and migration. PMID: 24370119
- The IFITM3 genotype is a primary driver of the observed differences in clinical outcome after H7N9 infection. PMID: 24367104
- The antiviral effector protein interferon-inducible transmembrane protein 3 (IFITM3) interacts with VAPA and prevents its association with OSBP. PMID: 23601107
- rs3888188, a functional promoter polymorphism of IFITM3, was identified to influence the risk for pediatric TB in Han Chinese population. PMID: 23874452
- Vesicular stomatitis virus and influenza A virus increased IFITM3-K88me1 levels by promoting the interaction between IFITM3 and SET7, suggesting that this pathway could be hijacked to support infection; conversely, IFN-alpha reduced IFITM3-K88me1 levels. PMID: 24129573
- IFITM3 protein was highly expressed in invasive breast cancer compared to normal tissues and was significantly associated with estrogen receptor and progesterone receptor status. PMID: 23624618
- Although their inhibitory activities were modest when compared to that of tetherin, IFITMs, but not tetherin, directly reduced the expression of HIV-1 proteins including Gag, Vif and Nef. PMID: 23376165
顯示更多
收起更多
-
亞細胞定位:Cell membrane; Single-pass type II membrane protein. Late endosome membrane; Single-pass type II membrane protein. Early endosome membrane; Single-pass type II membrane protein. Lysosome membrane; Single-pass type II membrane protein. Cytoplasm, perinuclear region.
-
蛋白家族:CD225/Dispanin family
-
數據庫鏈接:
Most popular with customers
-
YWHAB Recombinant Monoclonal Antibody
Applications: ELISA, WB, IHC, IF, FC
Species Reactivity: Human, Mouse, Rat
-
Phospho-YAP1 (S127) Recombinant Monoclonal Antibody
Applications: ELISA, WB, IHC
Species Reactivity: Human
-
-
-
-
-
-